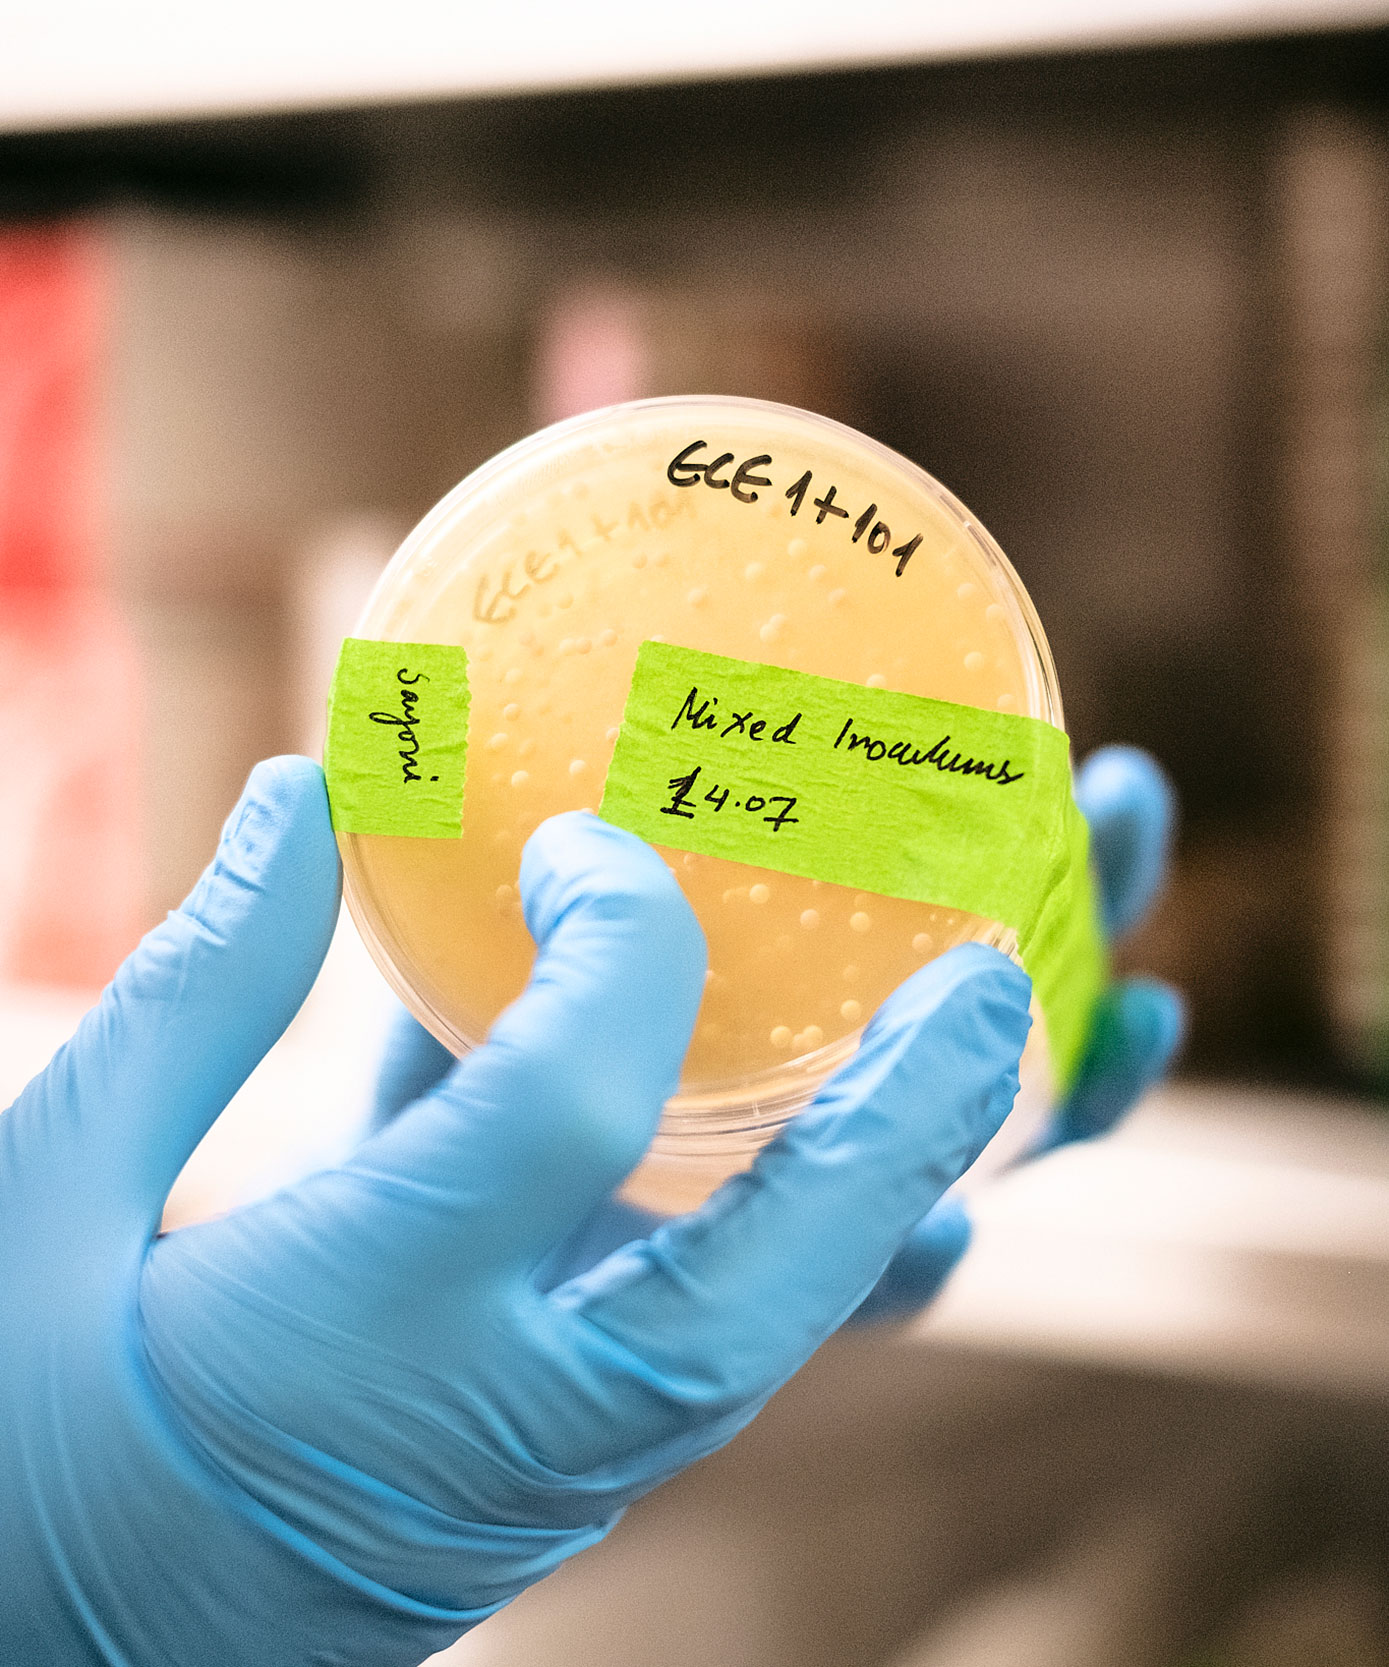
Entzündungsforschung und Mikrobiom-Technologien

Eine Anlaufstelle für Innovation und Transfer in Jena
JENAINNOVATION ist die übergreifende Initiative für Innovation und Wissenstransfer in Jena.
Wir unterstützen Forschende und Teams dabei, wissenschaftliche Erkenntnisse in konkrete Anwendung und Wirkung zu überführen. Dazu begleiten wir Innovationsprozesse von der ersten Idee bis zur Umsetzung und fördern die Zusammenarbeit zwischen Wissenschaft, Wirtschaft und weiteren gesellschaftlichen Partnern. So tragen wir dazu bei, Jena als führende Innovationsregion zu profilieren.
Unterstützung entlang des gesamten Innovationspfades
Innovation und Transfer sind vielfältig, genauso wie die Wege, auf denen Forschung wirkt. JENAINNOVATION begleitet unterschiedliche Vorhaben, von der ersten Orientierung bis zur Umsetzung:
- Kooperationen zwischen Wissenschaft und Wirtschaft
- Praktische Anwendungen und Reallabore
- Kompetenzaufbau, Methodenentwicklung und Vernetzung
- Ausgründungen und unternehmerische Vorhaben
- Validierung und Prototyping
- Mentoring und individuelle Begleitung
Aktuelle Einblicke
Events
07.05.26

14:30 – 21:00 Uhr / Vorträge, Workshops, Vernetzung
Normannenhaus
20.05.26

14:14 – 15:45 Uhr / Vortrag, Austausch
Abbe Center of Photonics building, Campus Beutenberg
10.09.26

17:00 – 21:00 Uhr / Pitch, Vernetzung, Party
imaginata
Unser Team

Ede Möser
Leitung
Mail
+49 3641 9-402123

Dr. Michael Biermann
Innovation Scouting
Mail
+49 3641 205 593

Christian Kauhaus
Innovation Scouting
Mail
+49 3641 205 937

Gabriel Dörner
Kommunikations- und Veranstaltungsmanagement
Mail
+49 3641 9-401120

Toni Wille
Innovation Scouting
Mail
+49 3641 205 378